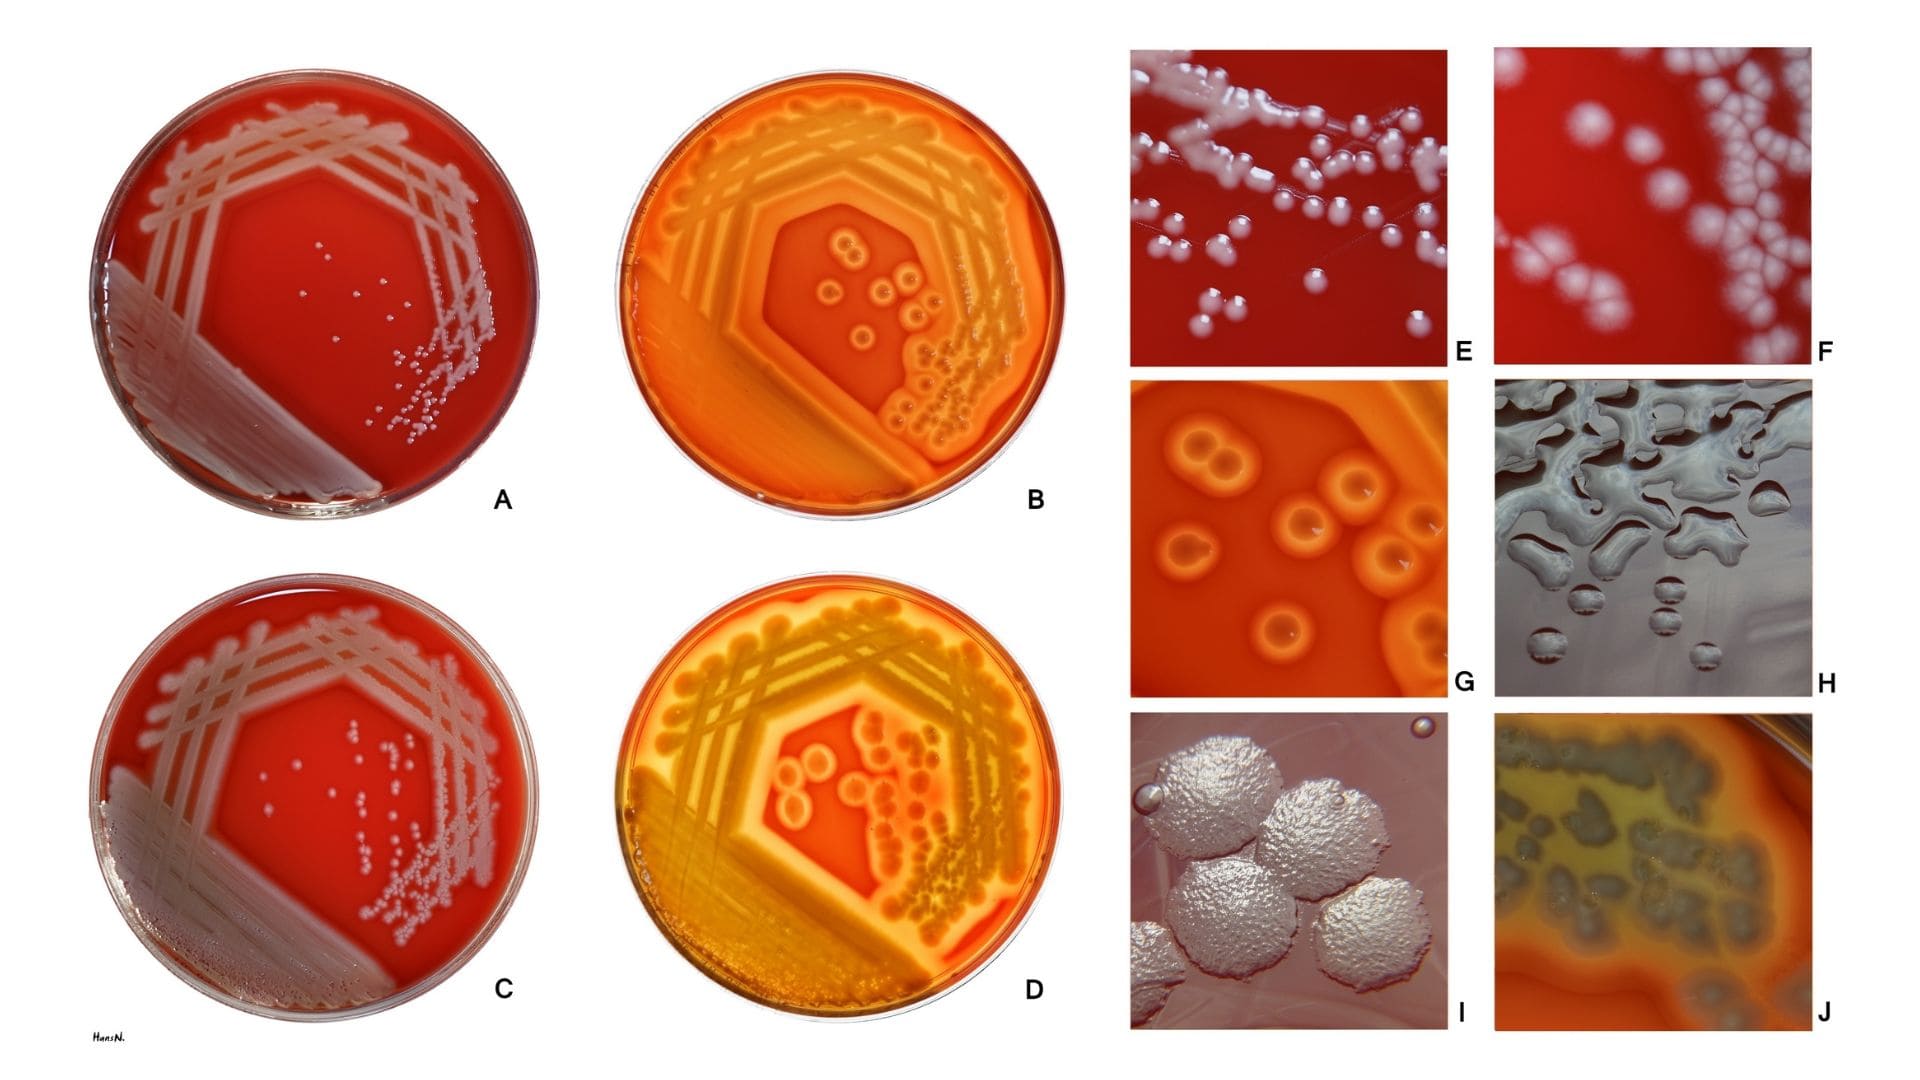
Pseudomonas aeruginosa

Bahaya Bakteri pada Air Keran: Mengungkap Risiko Kesehatan dan Jenis Bakteri yang Ditemukan
Air keran merupakan sumber air utama bagi banyak rumah tangga di seluruh dunia. Meskipun telah melalui berbagai proses penyaringan dan disinfeksi, air keran masih dapat mengandung berbagai jenis bakteri yang berpotensi membahayakan kesehatan manusia. Artikel ini akan membahas bahaya bakteri pada air keran, jenis-jenis bakteri yang umumnya ditemukan, serta dampak kesehatannya.
Jenis-Jenis Bakteri pada Air Keran
Escherichia coli (E. coli)

E. coli adalah bakteri yang biasanya ditemukan di usus hewan berdarah panas, termasuk manusia. Kehadirannya dalam air menunjukkan kontaminasi tinja. Strain tertentu dari E. coli dapat menyebabkan infeksi serius seperti diare berdarah, kram perut, dan muntah. Salah satu strain yang terkenal adalah E. coli O157, yang dapat menyebabkan komplikasi serius seperti sindrom uremik hemolitik (HUS).
Legionella pneumophila

Bakteri ini dapat ditemukan dalam sistem air panas dan pendingin, serta menara pendingin. Legionella pneumophila menyebabkan penyakit legionellosis, yang meliputi Legionnaires’ disease (penyakit Legionnaires) dan Pontiac fever. Legionnaires’ disease adalah bentuk pneumonia yang serius, sedangkan Pontiac fever adalah infeksi ringan dengan gejala mirip flu.
Salmonella spp

Bakteri ini sering terkait dengan keracunan makanan tetapi juga dapat ditemukan dalam air yang terkontaminasi. Salmonella menyebabkan salmonellosis, dengan gejala termasuk diare, demam, dan kram perut. Pada kasus yang parah, infeksi dapat menyebar dari usus ke aliran darah dan menyebabkan komplikasi yang lebih serius.
Pseudomonas aeruginosa
Bakteri ini dapat hidup dalam berbagai lingkungan air, termasuk air keran. Pseudomonas aeruginosa adalah patogen oportunistik yang dapat menyebabkan infeksi serius pada individu dengan sistem kekebalan tubuh yang lemah. Infeksi kulit, infeksi saluran kemih, dan infeksi paru-paru seperti pneumonia adalah beberapa contoh infeksi yang disebabkan oleh bakteri ini.
Campylobacter spp

Bakteri ini adalah salah satu penyebab utama diare akibat bakteri di seluruh dunia. Infeksi Campylobacter, yang dikenal sebagai campylobacteriosis, ditandai dengan diare (sering berdarah), demam, dan nyeri perut. Bakteri ini sering ditemukan di air yang terkontaminasi tinja hewan atau manusia.
Vibrio cholerae

Bakteri ini adalah agen penyebab kolera, penyakit yang ditandai dengan diare berat dan dehidrasi. Kolera dapat menyebar melalui air minum yang terkontaminasi. Tanpa perawatan yang cepat, kolera dapat berakibat fatal karena dehidrasi yang cepat dan parah.
Bahaya Kesehatan dari Bakteri pada Air Keran
Kehadiran bakteri patogen dalam air keran dapat mengakibatkan berbagai masalah kesehatan, yang bervariasi dari infeksi ringan hingga penyakit serius yang dapat berakibat fatal. Berikut adalah beberapa bahaya kesehatan utama yang terkait dengan bakteri dalam air keran:
Infeksi Gastrointestinal
Banyak bakteri dalam air keran dapat menyebabkan infeksi saluran pencernaan, yang ditandai dengan gejala seperti diare, mual, muntah, dan kram perut. Infeksi ini dapat sangat berbahaya bagi anak-anak, orang tua, dan individu dengan sistem kekebalan tubuh yang lemah.
Penyakit Sistemik
Beberapa bakteri, seperti Salmonella dan E. coli, dapat menyebar dari usus ke aliran darah, menyebabkan sepsis dan infeksi sistemik lainnya. Ini bisa berakibat fatal jika tidak segera ditangani dengan antibiotik.
Infeksi Paru-paru
Bakteri seperti Legionella pneumophila dapat menyebabkan pneumonia berat, terutama pada orang dewasa yang lebih tua dan individu dengan kondisi kesehatan kronis. Penyakit Legionnaires memiliki tingkat kematian yang signifikan jika tidak segera diobati.
Infeksi Kulit dan Jaringan Lunak
Pseudomonas aeruginosa dapat menyebabkan infeksi kulit dan jaringan lunak, termasuk dermatitis dan infeksi luka. Bakteri ini juga dapat menyebabkan infeksi pada pasien rumah sakit, seperti infeksi luka bedah dan infeksi pada kateter.
Penyakit Kronis
Paparan jangka panjang terhadap air yang terkontaminasi bakteri dapat menyebabkan masalah kesehatan kronis. Misalnya, infeksi kronis oleh Pseudomonas aeruginosa dapat mengakibatkan bronkitis kronis atau memperburuk kondisi paru-paru pada pasien dengan penyakit paru obstruktif kronis (PPOK).
Pencegahan dan Pengendalian
Untuk mengurangi risiko infeksi akibat bakteri dalam air keran, beberapa langkah pencegahan dapat diambil:
- Sistem Disinfeksi yang Efektif: Memastikan sistem penyaringan dan disinfeksi air berfungsi dengan baik. Klorinasi dan penggunaan ultraviolet adalah metode umum yang efektif untuk membunuh bakteri patogen.
- Pemeliharaan Infrastruktur: Memastikan pemeliharaan yang baik pada jaringan pipa dan infrastruktur air untuk mencegah kontaminasi.
- Pengawasan Rutin: Melakukan pengujian rutin terhadap kualitas air untuk mendeteksi adanya bakteri patogen.
- Edukasi Masyarakat: Mengedukasi masyarakat tentang pentingnya kebersihan dan cara-cara menghindari kontaminasi air, seperti tidak menggunakan air keran langsung untuk minum tanpa merebusnya terlebih dahulu.
- Jasa Klin Water: Menggunakan layanan profesional seperti Klin Water yang menawarkan jasa kuras toren dan detox pipa air bersih. Kuras toren membantu menghilangkan endapan dan kontaminan yang menumpuk di tangki air, sementara detox pipa air bersih memastikan pipa bebas dari bakteri dan kotoran, sehingga kualitas air yang diterima lebih terjamin kebersihannya.
Air keran tanpa melalui proses pengolahan, masih berisiko mengandung berbagai jenis bakteri patogen yang dapat menyebabkan masalah kesehatan serius. Pemahaman tentang jenis-jenis bakteri yang umum ditemukan dalam air keran dan bahaya kesehatannya sangat penting untuk mengambil langkah-langkah pencegahan yang tepat. Melalui upaya bersama dalam pengelolaan air dan edukasi masyarakat, risiko infeksi dapat diminimalkan, dan kesehatan masyarakat dapat lebih terjaga.
Untuk menjaga kesehatan keluarga Anda dan memastikan air yang Anda gunakan bebas dari kontaminasi bakteri, pertimbangkan untuk menggunakan jasa Klin Water. Layanan profesional mereka dalam kuras toren dan detox pipa air bersih dapat membantu memastikan air yang Anda gunakan aman dan higienis. Hubungi Klin Water sekarang untuk informasi lebih lanjut dan jadwal layanan!




